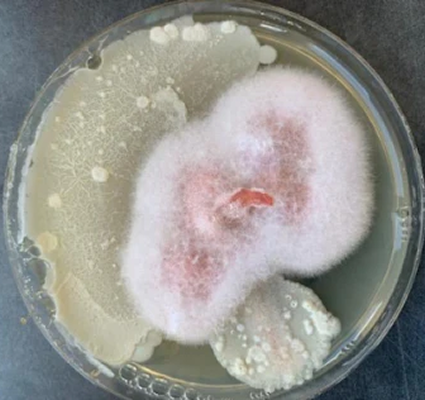
germen visto en una placa de petri
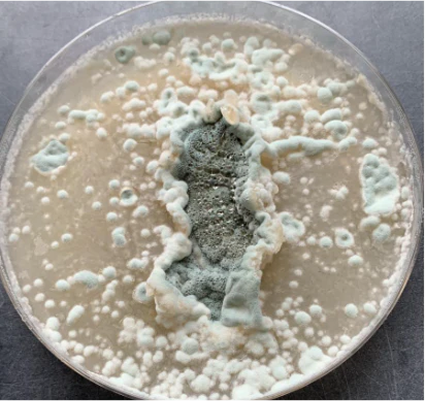
moho visto desde una placa de petri

Creciendo de manera natural
El gran poder de la naturaleza
En Bio World Organic, entendemos que la agricultura es un arte y una ciencia que requiere atención, dedicación y un enfoque responsable hacia el medio ambiente. Nos especializamos en ofrecer soluciones biotecnológicas innovadoras, como BWO Agricultura, que transforman la forma en que los agricultores cultivan y cosechan, permitiendo un desarrollo más sostenible y eficiente.
Beneficios de nuestras soluciones:
- Sanidad Vegetal: Refuerza la defensa natural de las plantas contra enfermedades fúngicas y nematodos, promoviendo un desarrollo saludable.
- Vigor y Crecimiento: Estimula un crecimiento robusto, aumentando la producción y calidad de la cosecha.
- Sostenibilidad: Fomenta prácticas agrícolas que respetan el medio ambiente, contribuyendo a la biodiversidad y al equilibrio ecológico.
BWO Agricultura
Este producto a base de microorganismos vivos mejora la salud del suelo al restaurar su biodiversidad. BWO Agricultura trabaja en sinergia con las plantas, facilitando la absorción de nutrientes y promoviendo un crecimiento vigoroso y saludable.
Su aplicación es especialmente efectiva en la prevención y control de problemas fúngicos y nematodos, ayudando a proteger tus cultivos de enfermedades y plagas, lo que se traduce en una mayor sanidad vegetal.

Fusarium Oxysporum
Inhibición de Fusarium Oxysporum
Pruebas realizadas tanto en laboratorio como en campo han demostrado que BWO Agricultura inhibe eficazmente Fusarium oxysporum.
Este hongo es conocido por causar enfermedades devastadoras en los cultivos, pero con BWO Agricultura, se obtiene un preventivo comprobado contra la raíz rosada y Fusarium, garantizando un mayor rendimiento por hectárea y una sanidad óptima.
Raíz Rosada
Gracias a la aplicación de BWO Agricultura desde el inicio del cultivo de cebolla, se ha logrado inhibir el hongo Pyrenochaeta terrestris, obteniendo resultados óptimos en la prevención de la raíz rosada.
Esto se traduce en cebollas más saludables y productivas.

Penicillium
Al aplicar BWO Agricultura, puedes abordar de manera efectiva los problemas causados por Penicillium lilacinum.
Este producto no solo inhibe la presencia de este hongo, sino que también promueve un ambiente más saludable para el crecimiento del ajo, mejorando su sanidad vegetal y vigor.
La aplicación desde el inicio del cultivo asegura que los microorganismos beneficiosos estén presentes en el suelo, ayudando a prevenir la proliferación de hongos patógenos
Moteado del Manzano
La enfermedad del moteado en los manzanos, provocada por el hongo Venturia inaequalis, ha sido revertida gracias a la acción de los microorganismos presentes en BWO Agricultura.
Diversas pruebas y ensayos han demostrado que la aplicación de nuestro producto proporciona una protección efectiva contra esta enfermedad, asegurando la salud y la productividad de los manzanos.

Ditylenchus dipsaci
Estadística de Nemátodos en Cultivos de Ajo 2023/2024
La aplicación de BWO Agricultura desde el inicio del cultivo ha mostrado resultados prometedores en la reducción de nemátodos patógenos.
En particular, se ha registrado una disminución significativa de Ditylenchus dipsaci, llevando la incidencia a niveles muy reducidos.
Puedes visitar nuestro documento sobre la estadística de incidencia de nemátodos para más información.

